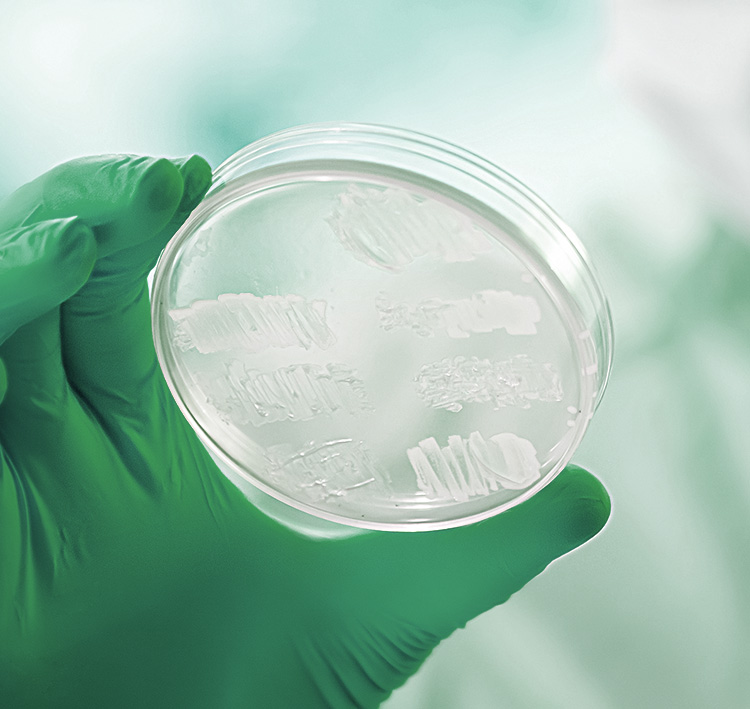

R&D and Production Agency
마이크로솔루션은 풍부한 발효 공정 기술과 경험을 바탕으로 농축산용 미생물의 연구개발 및 발효생산 대행을 하고 있습니다.
고객은 판매에 집중할 수 있도록 품질 개선과 공정개선을 통해 경쟁력 있는 제품 및 원료를 제공합니다.
Fermentation process skills and experience

Microbial technology
'미생물은 노력하는 자를 배신하지 않는다'
마음가짐으로 최선의 미생물 솔루션을 제공합니다.
궁금한 사항이 있으시다면,
문의를 남겨 주세요.
Advisor가 곧 연락드리겠습니다.
ABOUT US
풍부한 발효 공정 기술과 경험을 바탕으로
농축산용 미생물의 연구개발 및 발효생산 대행
고객은 판매에 집중하고 마이크로솔루션은 품질 개선 및
공정개선을 통해 경쟁력 있는 제품을 제공합니다